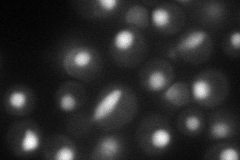
YLR005W
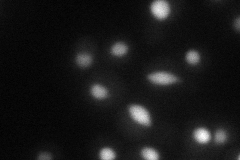
YLR005W
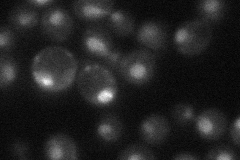
YLR005W
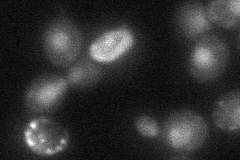
YLR005W

View description
Component of the core form of RNA polymerase transcription factor TFIIH, which has both protein kinase and DNA-dependent ATPase/helicase activities and is essential for transcription and nucleotide excision repair; interacts with Tfb4p
Localization:
Intensity:
Fold change:
Significance:
-
C’ GFP library in SD

nucleus22.77 -
N' NOP1pr-GFP in SD
nucleus67.3176 -
N' TEF2pr-mCherry in SD
nucleus28.5248 -
N' NATIVEpr-GFP in SD
nucleus29.9636 -
N' TEF2pr-VC and Cyto-VN in SD
nucleus30.6589 -
C’ GFP library in SD+DTT

nucleus24.911.09No -
C’ GFP library in SD+H2O2

nucleus25.471.11No -
C’ GFP library in Starvation Media

nucleus19.350.84No -
C’ GFP library on the background of Pup2-DaMP

nucleus -
C’ GFP library on the background of CCT mutant

nucleus21.34290.936846No
